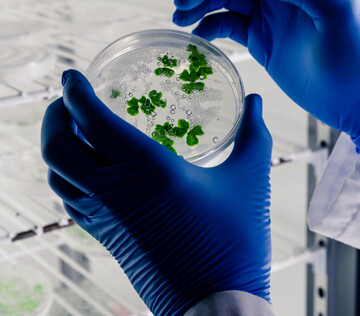
Терапия оксидом азота показала высокую эффективность против устойчивых бактерий

Разработан тест для быстрого выявления Helicobacter pylori
Дата публикации: 31 января 2026Ученые Роспотребнадзора разработали и зарегистрировали новый ПЦР-тест для выявления бактерии Helicobacter pylori, вызывающей гастрит. Тест обнаруживает ДНК возбудителя с высокой точностью и подходит д...